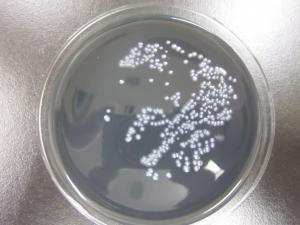
レジ

理化学課
食品薬品担当の主な業務
食品安全対策事業に係る検査
福島県食品衛生監視指導計画に基づき、保健所が収去・買い上げを行った県内流通食品の検査を実施しています。
- 加工食品等の放射性物質検査 ( 検査手順 [PDFファイル/322KB] )
検査結果 ( クリックすると「ふくしま復興ステーション」の関連ページが開きます。 ) - 食品中の残留農薬検査
- 防カビ剤検査・貝毒検査(麻痺性、下痢性)
- 畜水産食品中の抗生物質等モニタリング検査
- 流通米のカドミウム検査
- 遺伝子組換え食品検査
ゲルマニウム半導体検出器 ガスクロマトグラフ・タンデム型質量分析計 高速液体クロマトグラフタンデム型質量分析計
(GC/MS/MS) (LC/MS/MS)


加工食品や水道水等の放射性物質検査に 農作物中の残留農薬検査及び畜水産物中の動物用医薬品検査に使用しています。
使用しています。
医薬品安全対策事業に係る検査
ダイエット用食品や強壮用食品等の無承認医薬品による健康被害の発生を未然に防止するため、買い上げ検査に対応できる検査体制を維持します。厚生労働省からの依頼に基づく後発医薬品品質確保対策のため、流通製品の溶出試験を実施しています。
- 医薬品含有(疑)食品等検査
- 後発医薬品品質確保対策(溶出試験)
溶出試験器
後発医薬品の品質確保のため、溶出率の検査に使用しています。
生活科学担当の主な業務
飲料水中の放射性物質モニタリング検査
福島県飲料水の放射性物質モニタリング検査に基づき、県内の飲料水を対象とした放射性物質検査を実施しています。
- 検査結果 ( クリックすると「ふくしま復興ステーション」の関連ページが開きます。 )
飲料水の水質検査
一般からの依頼に基づき、飲料水(井戸水)の水質検査を実施しています。【有料】 ※受付日、料金については別途御相談願います。
ICP-MS(高周波誘導結合プラズマ質量分析計)

飲料水に含まれる金属類の元素を一斉に分析する測定機器です。
浴槽水のレジオネラ属菌検査
旅館や公衆浴場の浴槽水については、県条例においてレジオネラ属菌等の基準が定められております。レジオネラ症の集団発生の未然防止のため、保健所が採水した旅館・公衆浴場の浴槽水等の検査を行っています。
培地上のレジオネラ属菌 実体顕微鏡で観察したレジオネラ属菌

家庭用品安全対策事業に係る検査
「有害物質を含有する家庭用品の規制に関する法律」に基づき、保健所の買い上げした市販品にかかる家庭用品(繊維製品・家庭用洗浄剤)の規格適否試験(ホルムアルデヒド等)を行っています。
試験品は衣料品や洗浄剤などの生活用品を扱っています。
その他
温泉法第十九条に基づく温泉成分分析施設の登録を受けています。